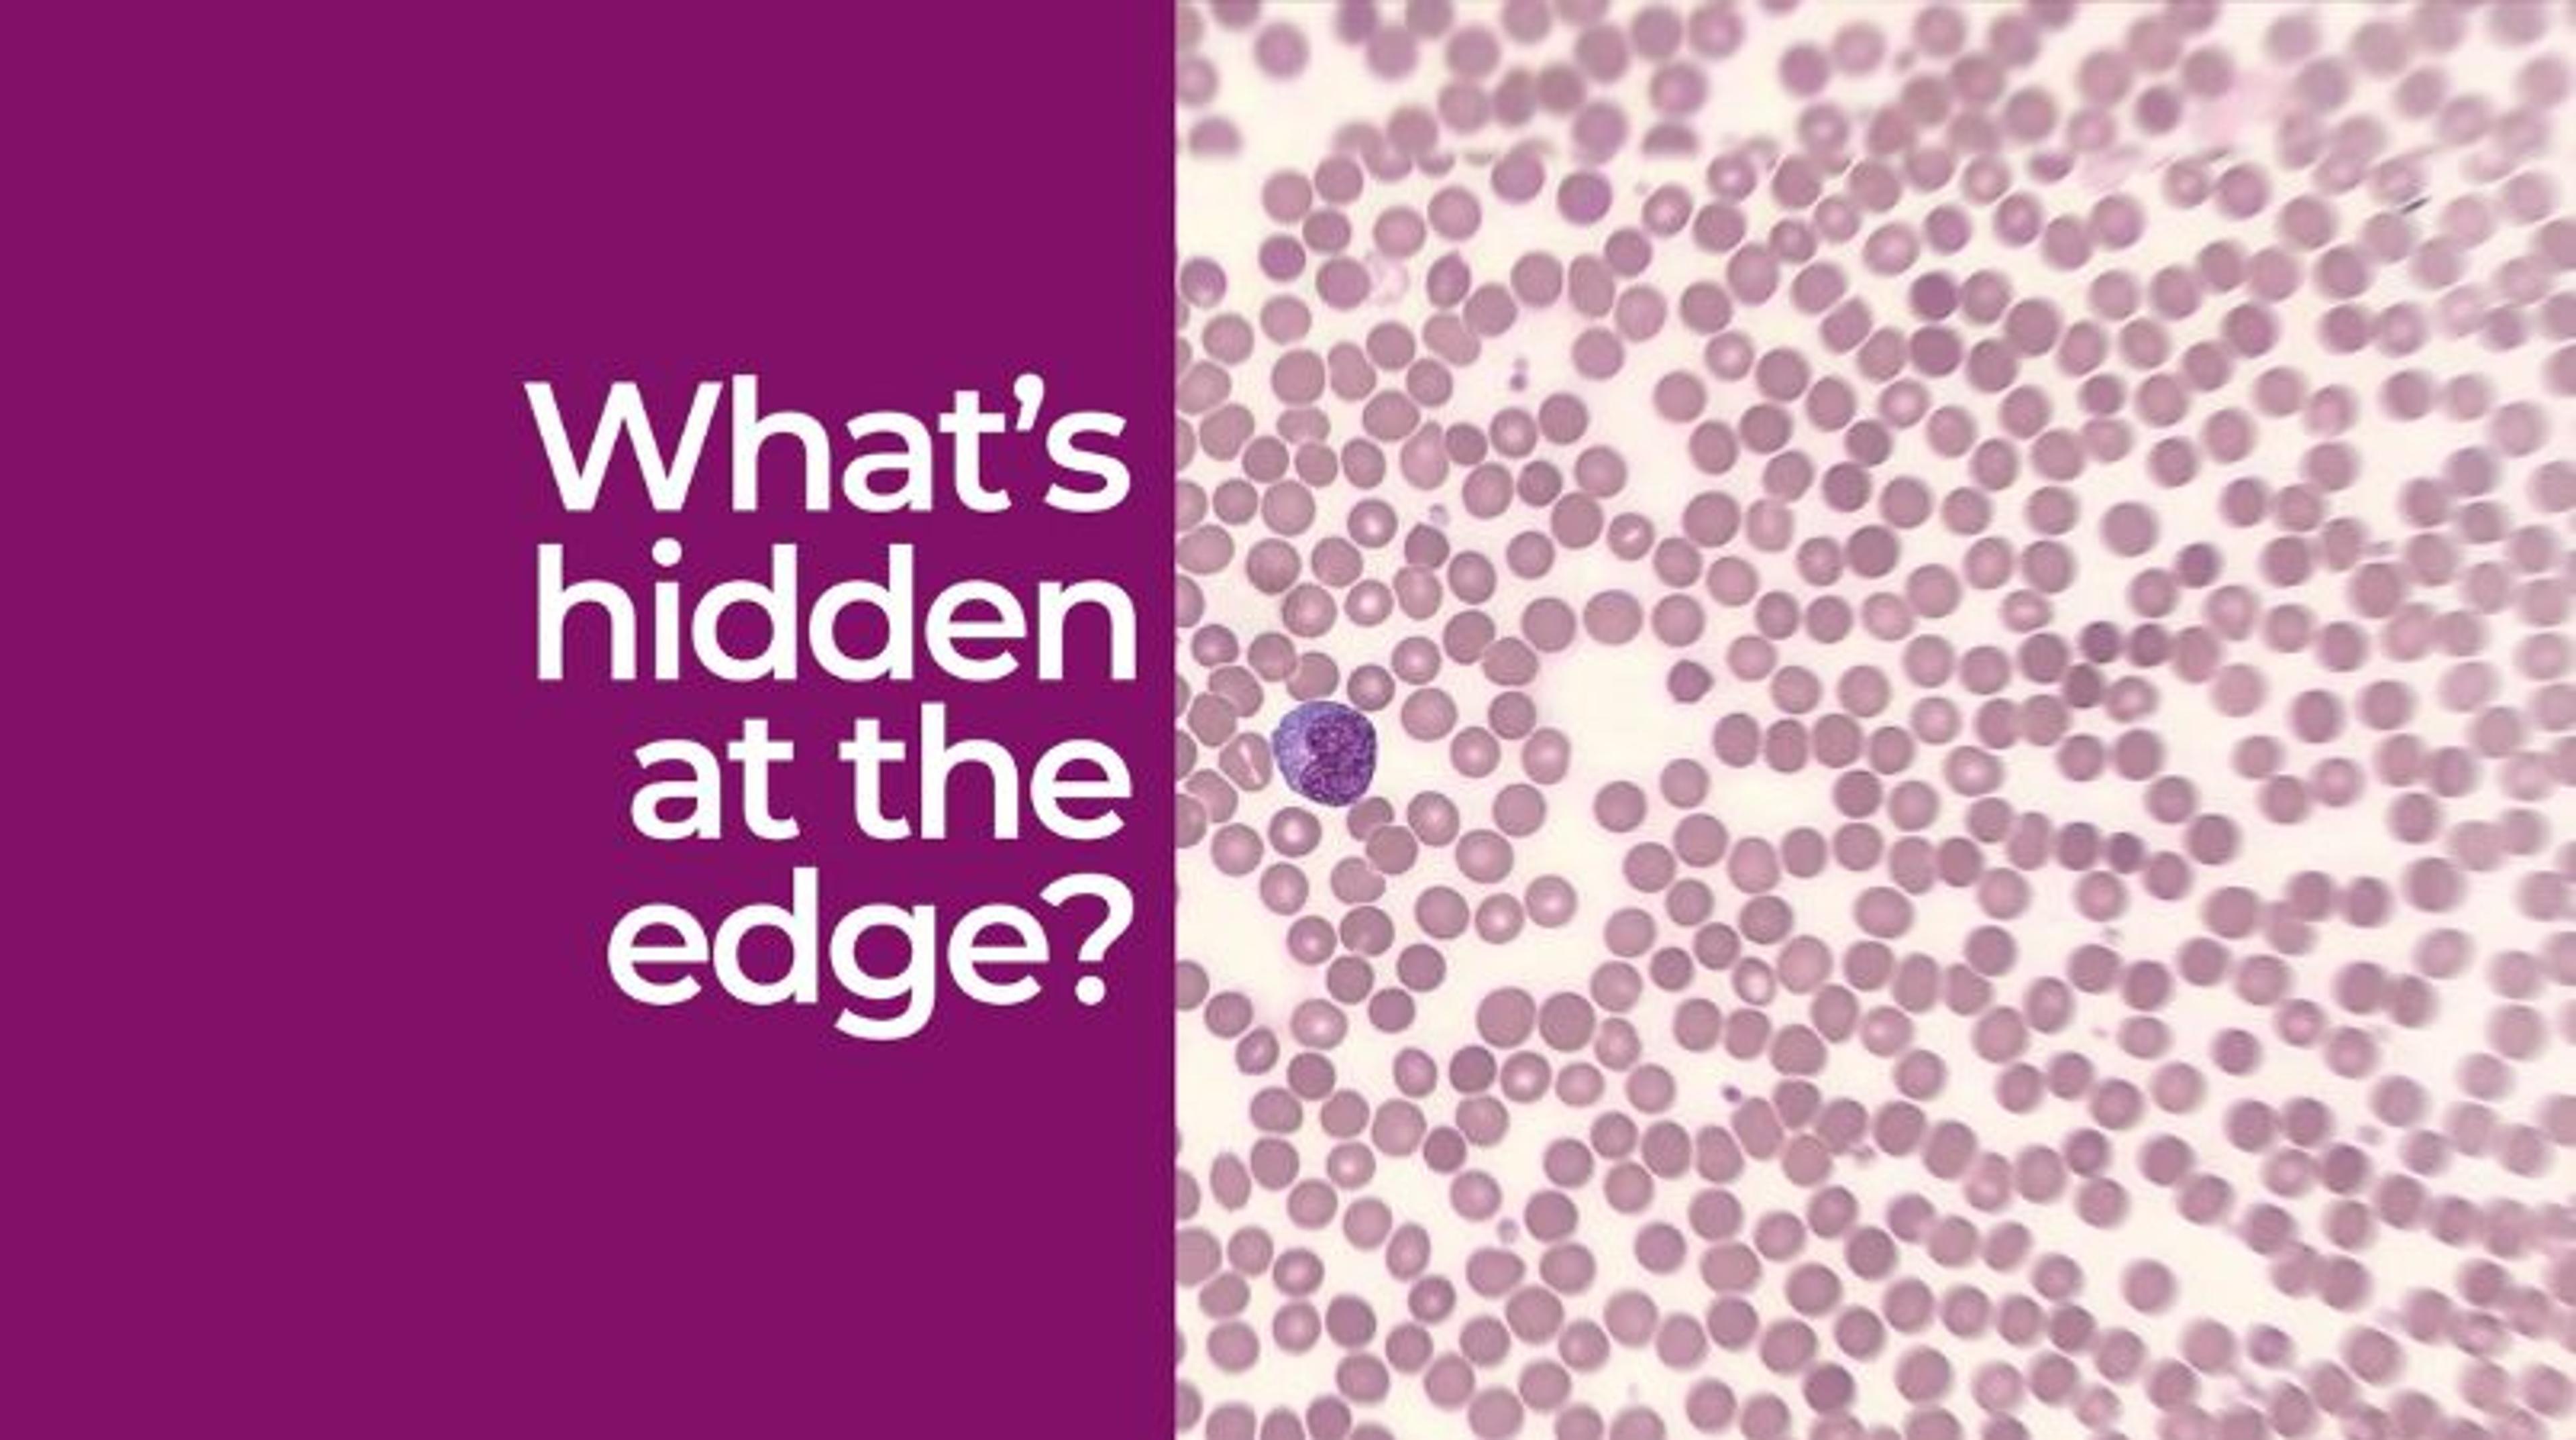

Product DemonstrationsDrug discovery > Basic Research
Scopio labs' full-field view technology unveiled
9 Aug 2023
In this video, Beckman Coulter highlights how Scopio Labs' full-field view technology assists clinicians in gaining enhanced insights and answers compared to the conventional snapshot view. It addresses issues like platelet clumps, malignant cells, and parasitic infections.